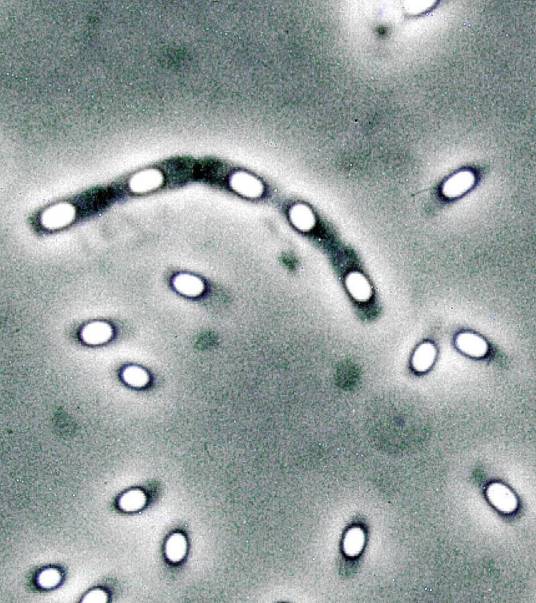

-
乳酸克鲁维酵母 编辑
乳酸克鲁维酵母(Kluyveromyces lactis)是克鲁维酵母属下的一种酵母菌,研究开始于上世纪50年化末。当时获得的大部分该酵母菌株都分离自系列的牛奶制品中,如马奶酒、希腊奶酪等乳制品。Vander Walt首先在1956年创建了克鲁维酵母属,乳酸克鲁维酵母的名称是为了纪念荷兰微生物学家Albert Jan Kluyver(1888-1956)而命名的。
乳酸克鲁维酵母是生物技术科学领域非常重要的非酿酒酵母之一,其意义主要体现在两个方面:在食品行业中安全应用的历史和工业规模化生产酶的能力。
拉丁学名:Kluyveromyces lactis
界:真菌界
门:子囊菌门
亚门:醇母菌亚门
纲:酵母纲
目:酵母菌目
科:酵母科
属:克鲁维酵母属
种:乳酸克鲁维酵母
中文学名:乳酸克鲁维酵母
 乳酸克鲁维酵母的细胞形态
乳酸克鲁维酵母的细胞形态
乳酸克鲁维酵母在培养时,会发散出特别的类似水果的香气,因此很容易与酿洒酵母及其他酵母如毕赤酵母的培养物区分开。水果香气的产生说明乳酸克鲁维酵母在发酵培养过程中产生了有机的酸性醋类物质。大多数的乳酸克鲁维酵母菌株在严格的厌氧条化下培养并不能够生长,即使在培养基中加入留醇类和脂肪酸类物质也不能改变这种情况。
在好氧条件下培养时,乳酸克鲁维酵母可以发酵代谢葡萄糖从而形成乙醇,而与此同时乳酸克鲁维酵母的有氧代谢呼吸系统在其生长过程中同样行使功能,这与在酿酒醇母中发生的情况有非常人的区别。乳酸克鲁维酵母中的有氧代谢呼吸系统对葡萄糖抑制现象并不敏感。实际上除了粟酒裂殖酵母之外,许多通常被认为是专性好氧菌的"阴性小幽落酵母",都不会受到葡萄糖抑制作用的影响。当酿酒酵母在葡萄糖培养基上生长时,即使在有氧培养条件下也还是以乙醇发酵代谢为主,只有当培养基中的葡萄糖含量接近耗尽时,有氧呼吸代谢途径才被诱导激活。这与乳酸克鲁维酵母在巧氧条件下对葡萄糖的利用有非常明显的差异。
乳酸克鲁维酵母能够利用的碳源非常广泛,纤维二糖、山梨糖、2,3-丁二醇等其他酵母不易利用的碳源在乳酸克鲁维酵母中都可以得到利用。在实验室的研究过程中,培养乳酸克鲁维酵母所巧用的培养条件一般与培养酿酒酵母所使用的培养条件相似。完全培养基成分为1%的酵母提取物(W/V)、2%的蛋白胨(W/V)及实验所需的碳源,一般为2%的葡萄糖(YPD培养基)或者2%的乳糖(YPL培养基)。乳酸克鲁维醇母通常的生长温度为25至30°C,温度上限通常为40’℃,而经过50°C,10 min的热冲击处理会导致大部分的乳酸克鲁维酵母死亡。作为一种子囊菌出芽酵母,乳酸克鲁维酵母的生命周期与酿酒酵母非常相似,但是也略有不同。乳酸克鲁维酵母通常为异宗配合,对应的两个接合巧分别为a驶和a型。在乳酸克鲁维酵母的生命周期中单倍体非常稳定而二倍体时期非常短暂且不稳定,培养中的二倍体细胞自发的形成孢子。通过在低营养含量的培养基中培养也可成功的获得孢子四分体,进而用于后续的筛选和分析实验。
乳酸克鲁维酵母在有氧的巧养条件下可以在半乳糖、乳糖、庶糖和遣巧糖等糖类的培养基中生长,而在氧气化用受限的低氧或无氧状态下则不能生长,这就所谓的"克鲁维效应"。这种现象的产生最巧的解释是乳酸克鲁维酵母在厌氧的条件下缺少运输糖类的能力。在严格的庆氧条件下乳酸克鲁维酵母不只是不能在葡萄糖中生长,而是不能在任何糖类中生长,即使在加入如麦角固醇和不饱和脂肪酸作为"存活因子"的培养条件下也是同样的结果。能够利用乳糖是乳酸克鲁维酵母的重要特性。乳酸克鲁维酵母对葡萄糖利用的初始磷酸化是通过RAG5基因编码的己糖激酶实现的。
 乳酸克鲁维酵母
乳酸克鲁维酵母
乳酸克鲁维酵母作为蛋白表达系统在食品行业的成功应用,意味着其也可以应用于医药行业进行大规模的药用蛋白的生产。事实上,许多药用相关蛋白已在乳酸克鲁维酵母中成功表达,比如哺乳动物蛋白白介素1-P、干扰素α、β-乳球蛋白、溶菌酶和胰岛素前体等。在医药领域的应用,乳酸克鲁维酵母(和其他酵母、真菌表达系统一样)的一个缺点就是对分泌的蛋白都会进行一定的糖基化修饰,并且这种修饰与人体内糖基化模式是不同的,这会对药用蛋白的半衰期、组织分布和免疫原性产生不利的影响。当然,通过改变酵母体内糖基化的方式,使其生产的蛋白能够满足人体内的糖基化模式,是可以使药用蛋白发挥效果的,这一有前景的技术对于乳酸克鲁维酵母也是适用的。
1、本站所有文本、信息、视频文件等,仅代表本站观点或作者本人观点,请网友谨慎参考使用。
2、本站信息均为作者提供和网友推荐收集整理而来,仅供学习和研究使用。
3、对任何由于使用本站内容而引起的诉讼、纠纷,本站不承担任何责任。
4、如有侵犯你版权的,请来信(邮箱:baike52199@gmail.com)指出,核实后,本站将立即删除。